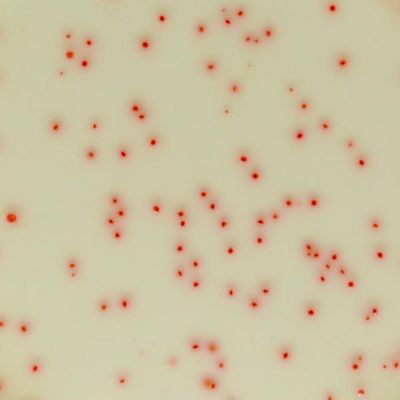

CHROMagar
5 products found
CHROMagar products
Food Industry
Model Chromagar - C. perfringens
Performance: Clostridium perfringens is involved in food poisoning and animals’ infections.Beef, poultry, gravies, and dried or pre-cooked foods are common sources of C. perfringens infections. C. perfringens infection often occurs when foods are prepared in large quantities and kept warm for a long time before serving. Although C. perfringens may live normally in the human intestine, illness is caused by eating food contaminated with large numbers of C. perfringens bacteria that produce enough toxin in the intestines to cause illness. Everyone is susceptible to food poisoning from C. perfringens. The very young and elderly are most at risk of C. perfringens infection and can experience more severe symptoms that may last for 1 to 2 weeks. Complications, including dehydration, may occur in severe cases. CDC - Centers for Disease Control and Prevention
Water Testing
AquaCHROM ECC
Performance: Coliforms, Enterobacteriacae able to ferment lactose, are bacteria present in human and warm blooded animals intestinal flora, in the soil and water. Coliforms are indicators of organic, environmental or faecal contamination. Strict regulations exist for E. coli/coliform abscence in water and food samples. This can be explained by the importance of these germs in determining water and food safety. Worldwide, water and food quality control for human consumption are based on detecting the presence/absence of E. coli and coliforms. E. coli can contaminate drinking water when the water treatment system is inadequate or during periods of very high rainfalls. Monitoring of food and water production is essential. Contamination may lead to suspension of the water supply and food recall by supermarkets.
CHROMagar - CCA
Performance: Coliforms, Enterobacteriacae able to ferment lactose (lactose positive Enterobacteriacae), are bacteria present not only in human and warm blooded animals intestinal flora but also in the soil and water. Coliforms are proof of organic, environmental or faecal contamination. Faecal contamination, due to coliforms coming from animal waste, consists mainly of Escherichia coli and thermotolerant Klebsiella. Strict regulations exist for E. coli/coliform presence in water samples. This can be explained by the importance of these germs in determining drinking water safety and process efficiency of treatment, storage and distribution.
CHROMagar - E.coli
Performance: Contamination by faecal material from animals can be shown by the detection of Escherichia coli in the sample. E. coli can contaminate drinking water when the water treatment system is inadequate or during periods of very high rainfalls. Monitoring of food and water production is essential. High contamination may lead to the suspension of the water supply or food recall by supermarkets. Concerning bathing water, regulations are more and more strict: • European directive from 1976: 2.000 Escherichia coli (E. coli) bacteria for 100 mL of water. • New directive in 2006: 500 E. coli per 100 mL. The presence of E. coli indicates faecal contamination and potential presence of dangerous pathogens such as bacteria like Vibrio cholerae, Salmonella, Pseudomonas etc…, or viruses and intestinal parasites.
CHROMagar - ECC
Performance: Coliforms, Enterobacteriacae able to ferment lactose (lactose positive Enterobacteriacae), are bacteria present in human and warm blooded animals intestinal flora, in the soil and water. Coliforms are proof of organic, environmental or faecal contamination. Faecal contamination, due to coliforms coming from animal waste, consists mainly of Escherichia coli and thermotolerant Klebsiella. Strict regulations exist for E. coli/coliform presence in water and food samples. This can be explained by the importance of these germs in determining water and food safety. E. coli can contaminate drinking water when the water treatment system is inadequate or during periods of very high rainfalls. Monitoring of food and water production is essential. High contamination may lead to suspension of the water supply and food recall by supermarkets